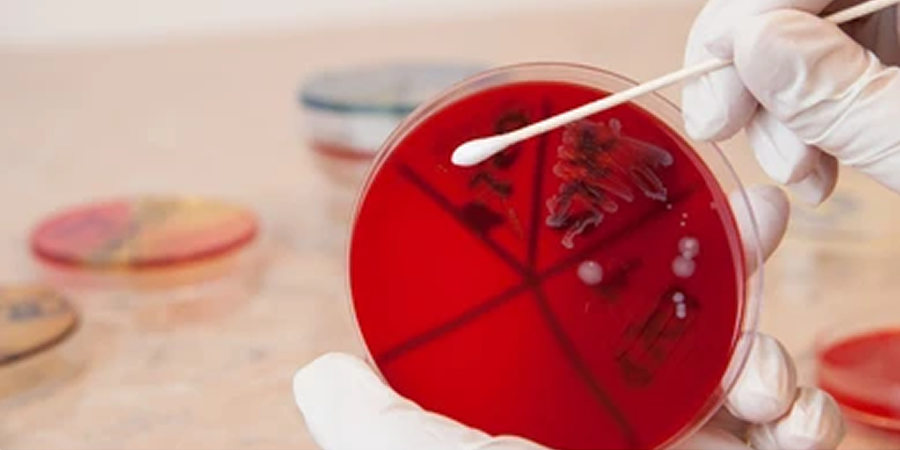

October 22, 2024
Study links majority of US campylobacteriosis cases to poultry, finds rising multidrug resistance
A recent study combining genomic data with machine learning has identified poultry as the leading source of campylobacteriosis cases in the US, with an increasing number of multidrug-resistant Campylobacter strains linked to human infections, Food Safety Magazine reported.
Published in the Journal of Infection, the study analysed genomic data from 8,856 isolates of Campylobacter jejuni and Campylobacter coli collected from confirmed human cases between 2009 and 2019. The data was collected by national and state laboratories, and compared against samples from livestock, animal food products, and poultry products, gathered through national surveillance programmes. The dataset was further supplemented by a global collection of genomes from wild birds and environmental sources.
Machine learning models were applied to this genomic data to identify the likely sources of each campylobacteriosis case. The analysis revealed that 92% of the 8,856 isolates from human cases were C. jejuni, while 8% were C. coli. Additionally, 16,703 isolates were collected from livestock and food products, of which 61% were C. jejuni and 39% were C. coli.
Most human cases (68.1%) were attributed to chicken, followed by cattle (27.9%). Though pork accounted for only a small percentage of overall cases, it was responsible for 17.1% of C. coli infections.
A significant rise in campylobacteriosis cases linked to poultry was noted, with poultry-related infections increasing from 22.8% in 2009 to 71% in 2018.
The study also highlighted a growing concern over multidrug-resistant strains of Campylobacter. The proportion of multidrug-resistant isolates increased from 12.3% in 2009 to 22.3% in 2018, driven largely by resistance to fluoroquinolones in human infections. Isolates associated with poultry harboured the most antimicrobial resistance (AMR) elements.
The researchers warned that the rise in campylobacteriosis cases attributed to poultry could lead to an increase in AMR in human infections. They emphasised that controlling infections from poultry could significantly reduce AMR in high-income countries like the U.S., where AMR is typically considered more stable.
- Food Safety Magazine










